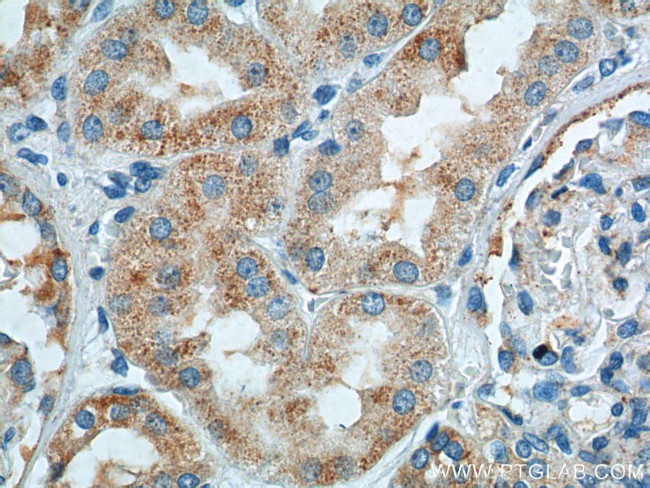
TTC17 Antibody in Immunohistochemistry (Paraffin) (IHC (P))
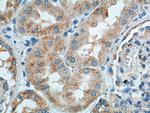
TTC17 Antibody in Immunohistochemistry (Paraffin) (IHC (P))

Search
Proteintech
TTC17 Polyclonal Antibody
{{$productOrderCtrl.translations['antibody.pdp.commerceCard.promotion.promotions']}}
{{$productOrderCtrl.translations['antibody.pdp.commerceCard.promotion.viewpromo']}}
{{$productOrderCtrl.translations['antibody.pdp.commerceCard.promotion.promocode']}}: {{promo.promoCode}} {{promo.promoTitle}} {{promo.promoDescription}}. {{$productOrderCtrl.translations['antibody.pdp.commerceCard.promotion.learnmore']}}
产品信息
25660-1-AP
种属反应
宿主/亚型
分类
类型
抗原
偶联物
形式
浓度
规格
纯化类型
保存液
内含物
保存条件
运输条件
产品详细信息
Immunogen sequence: GALEMKGRR LDLQGIRVLK KGPQDGVARS SCYGDCRSED DEATEWITFQ VKRVKKPKGD HKKTPGKKVE TGQIENGHRY QANLEITGPK VASPGPQGKK RDYQRLGWPS PDECLKLRWV ELTAIVSTWL AVSSKNIDIT EHIDFATPIQ QPAMEPLCNG NLPTSMHTLD HLHGVSNRAS LHYTGESQLT EVLQNLGKDQ YPQQSLEQIG TRIAKVLEKN QTSWVLSSMA ALYWRVKGQG KKAIDCLRQA LHYAPHQMKD VPLISLANIL HNAKLWNDAV IVATMAVEIA PHFAVNHFTL GNVYVAMEEF EKALVWYEST LKLQPEFVPA KNRIQTIQCH LMLKKGRRSP (793-1141 aa encoded by BC017238)
靶标信息
TTC17 is a protein coding gene.
仅用于科研。不用于诊断过程。未经明确授权不得转售。
篇参考文献 (0)
生物信息学
蛋白别名: Tetratricopeptide repeat protein 17; TPR repeat protein 17; unnamed protein product
基因别名: TTC17
UniProt ID: (Human) Q96AE7
Entrez Gene ID: (Human) 55761